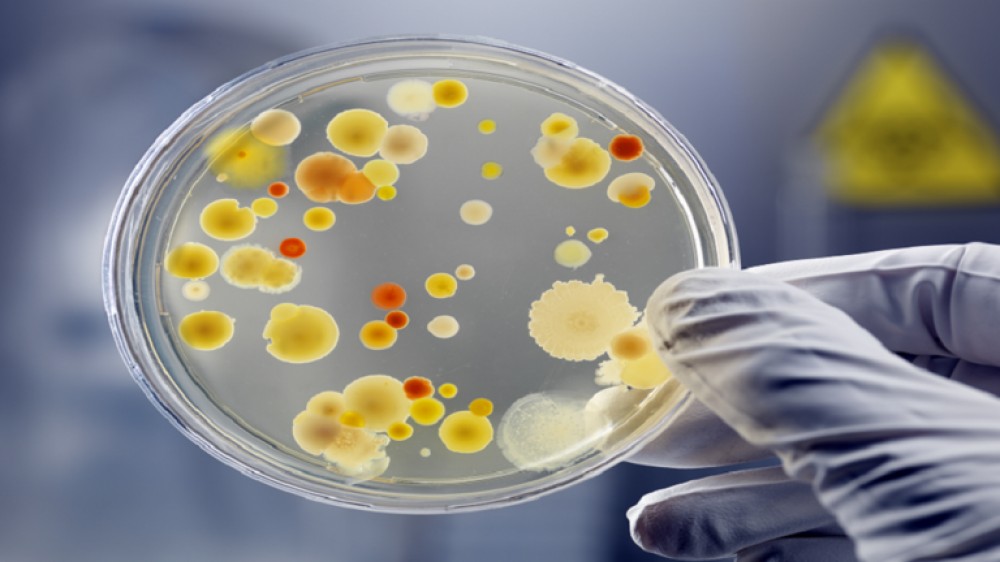
بكتيريا تحوّل ثاني أكسيد الكربون الموجود في الهواء إلى بلاستيك حيوي!

يمكن لبكتيريا معروفة أن تحول ثاني أكسيد الكربون من الهواء إلى بلاستيك حيوي، وتعالج مشكلتين عالميتين في خطوة واحدة سريعة، باستخدام نظام نموذج أولي صممه مهندسون كيميائيون في كوريا.
وجذبت البكتيريا التي تتغذى على البلاستيك، القادرة على تحطيم النفايات البلاستيكية في غضون ساعات، الكثير من الاهتمام مؤخرا كحل مجهري لمشكلة البلاستيك المتنامية في العالم.
وفي حين أن تنظيف الفوضى التي أحدثناها أصلا يمثل أولوية كبيرة، فإن البحث عن طرق جديدة لصنع البلاستيك من مصادر أخرى غير النفط الخام ومشتقاته أمر حيوي أيضا لتقليل اعتمادنا على الوقود الأحفوري. والبوليمرات البلاستيكية عبارة عن سلاسل طويلة من الوحدات الفرعية المكررة المتشابكة معا، وغالبا ما يكون العمود الفقري لهذه السلاسل هو ذرات الكربون.
وتمسك العديد من المهندسين الكيميائيين بالفكرة الساطعة القائلة بأن المستويات المتزايدة من ثاني أكسيد الكربون في الغلاف الجوي للأرض يمكن أن تكون موردا غير مستغل لصنع البلاستيك أو المنتجات الأخرى القائمة على الكربون، مثل وقود الطائرات أو الخرسانة - إذا تمكنا فقط من التقاط ثاني أكسيد الكربون من الهواء وصنع شيئا منه.
وتتمثل إحدى طرق تحويل غاز ثاني أكسيد الكربون إلى مركبات أخرى مفيدة تحتوي على الكربون عن طريق حقن الكهرباء في تفاعل يسمى التحليل الكهربائي. لكن هذه الطريقة، رغم أنها واعدة، إلا أنها تنتج في الغالب مركبات بداية قصيرة السلسلة تتكون من ذرة كربون واحدة إلى ثلاث ذرات كربون. ويعد صنع المواد الكيميائية ذات سلاسل الكربون الأطول من ثاني أكسيد الكربون مهمة أصعب وأكثر فاعلية.
وفي هذا الجهد الجديد، طور فريق من المهندسين الكيميائيين في المعهد الكوري المتقدم للعلوم والتكنولوجيا (KAIST) نظاما من جزأين لتحويل ثاني أكسيد الكربون إلى نوع شائع من البلاستيك الحيوي بمساعدة نوع بكتيري يسمى Cupriavidus necator. والخطوة الأولى في النظام هي المحلل الكهربائي الذي يحول غاز ثاني أكسيد الكربون إلى فورمات. ثم يتم إدخالها في خزان التخمير، حيث تعمل البكتيريا.
وتشتهر C. necator بقدرتها على تصنيع مركبات الكربون مثل poly-3-hydroxybutyrate أو PHB، وهو نوع من البوليستر القابل للتحلل الحيوي والسماد، من مصادر الكربون الأخرى.
وفي هذه الحالة، يلتهم C. necator المادة الخام للفورمات من تفاعل التحليل الكهربائي وحبيبات مخزون PHB - والتي يمكن بعد ذلك استخلاصها من الخلايا المحصودة.
ويدور نفس المحلول بين تفاعل التحليل الكهربائي وخزان التخمير، مع وجود غشاء يفصل بين الغرفتين بحيث يتم عزل البكتيريا عن المنتجات الثانوية لتفاعل التحليل الكهربائي.
وإذا كان النظام مدعوما بالطاقة المتجددة، فقد يكون طريقة خالية من الوقود الأحفوري لتوليد البلاستيك الحيوي الذي يستخدم في نفس الوقت ثاني أكسيد الكربون - والذي يجب إزالته بسرعة من الهواء للحد من التدفئة العالمية.
وأبدى كل من هونجو لي وسانغ يب لي، وهما مهندسان جزيئيان حيويان في KAIST اللذان قادا الدراسة، تفاؤلا بأن نهجهما قابل للتطوير ويمكن أن يقطع شوطا ما للمساعدة في تغيير طريقة تصنيع البلاستيك.
ويقولان إن "نتائج هذا البحث عبارة عن تقنيات يمكن تطبيقها على إنتاج مواد كيميائية مختلفة بالإضافة إلى البلاستيك الحيوي ومن المتوقع استخدامها كأجزاء رئيسية لازمة لتحقيق حيادية الكربون في المستقبل".
وأظهرت التجارب المعملية أن خلايا C. necator في النظام الهجين يمكنها تصنيع الكثير من PHB بحيث يمثل منتج البوليستر ما يصل إلى 83% من وزن الخلية الجافة للبكتيريا بعد 120 ساعة أو 5 أيام من التشغيل.
وبناء على هذه النتائج، يزعم الباحثون أن إعدادهم أكثر إنتاجية بمقدار 20 مرة من الأنظمة المماثلة التي تم اختبارها سابقا.
وأفاد الفريق أيضا أن نظامهم يمكن أن يعمل دون انقطاع طالما يتم تجديد الخلايا البكتيرية كل يوم وإزالة المنتج البلاستيكي للحفاظ على استمرار التفاعلات.
وسيكون هذا الإنتاج المستمر هو المفتاح لجعل النظام يعمل على المستويات الصناعية. حتى الآن، اختبرها الباحثون لمدة 18 يوما فقط وأنتجوا ما قيمته 1.45 غراما من البوليستر.
لكن الباحثين يقولون إن نظامهم المتكامل عبارة عن تحسين على المفاعلات الدفعية السابقة أو غيرها من التركيبات التي لا يمكنها تشغيل سوى مرحلة واحدة من التفاعل في كل مرة وتتطلب خطوات فصل وتنقية إضافية.
وفي غضون ذلك، يسعى مهندسو الكيمياء الحيوية الآخرون إلى تعزيز القدرة الطبيعية لـ C. necator على إنتاج PHB من ثاني أكسيد الكربون مع بعض التعديلات الجينية لأنهم يقولون إن كمية البوليمر التي تنتجها C. necator لا تزال منخفضة جدا للتسويق - على الأقل في الوقت الحالي.
نشرت الدراسة في PNAS.
المصدر: ساينس ألرت